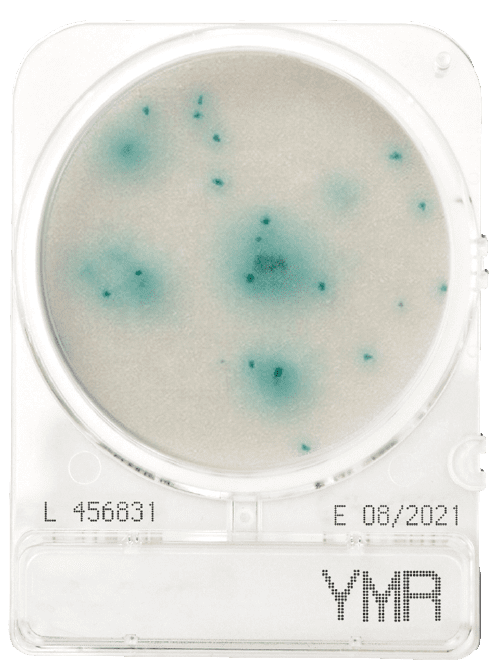

The US Food and Drug Administration (FDA) stipulates that yeast and mould testing is a release parameter for food and beverages, and is part of an environmental monitoring system through air sampling.
Yeast and mould can be present at any stage during food processing; from the crops in the field, storage of raw material, food preparation, and finished products.
Yeast and mould are generally spore forming microorganisms, and these spores are resistant to harsh conditions such as extreme pH, drought, and temperature. Yeast and mould count indicates environmental cleanliness of production areas.
Due to their high tolerance to environmental conditions, failure to detect yeast and mould in production areas can result in food spoilage.